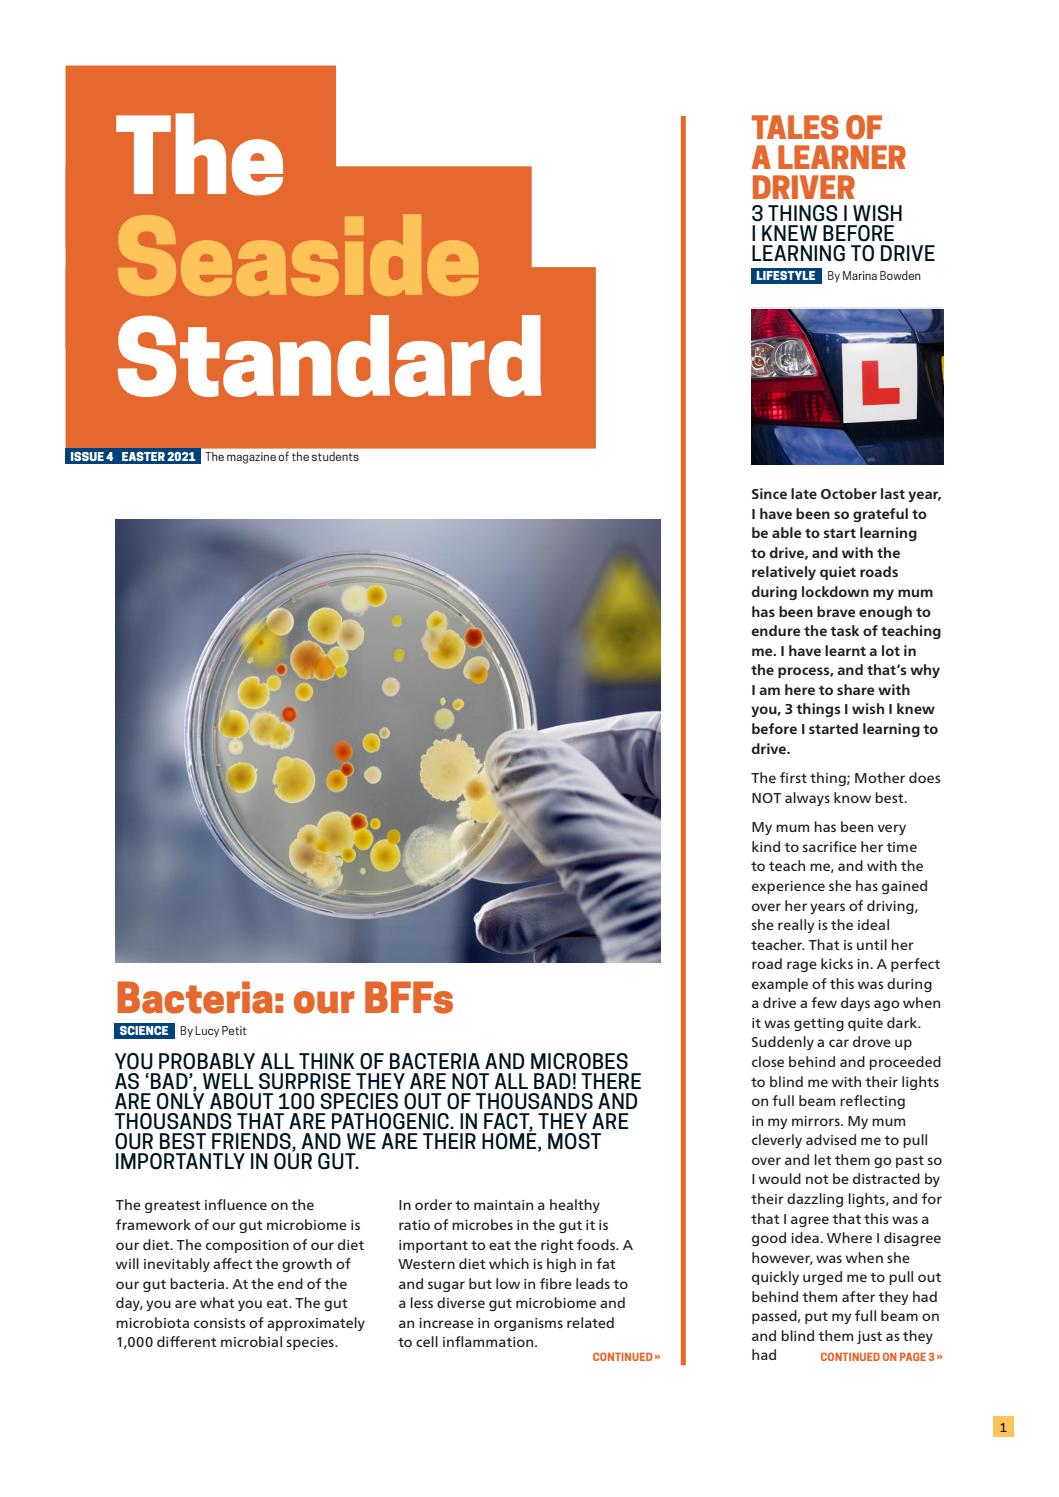

Lussy M In Wish You Were Here

β‘ ππ»ππ»ππ» FOR MORE INFORMATION, CLICK HERE ππ»ππ»ππ»
Malay sex gp
Exotic pornstars Matt Bird, Stefanie in Hottest DP, Threesomes porn clip
Aino Kishi Uncensored
Lesbian Teens Free
Kate glass fucking
Russian Brazzers Com
Private Key Program
Lussy M In Wish You Were Here














800_CR200">50">1200">630_CLa%7C1200">630%7C51JR8PygyGL.jpg%7C0">0">1200">630+82">82">465">465_PJAdblSocialShare-Gradientoverlay-largeasin-0to70">TopLeft">0">0_PJAdblSocialShare-AudibleLogo-Large">TopLeft">600">270_OU01_ZBLISTENING%20ON">617">216">52">500">AudibleSansMd">30">255">255">255.jpg">












0">970">300_PT0_SX970_V1___.jpg">
imgsize-829939">width-400">height-300">resizemode-75/88315221.jpg">

1">140">207_.jpg">


0">970">300_PT0_SX970_V1___.jpg">













630_.jpg">





0">300">300_PT0_SX300_V1___.jpg">















0">1162">1162_UX256.jpg">